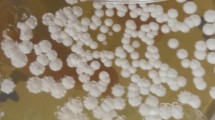

Abstract
The genus Streptomyces is a widespread genus within the phylum Actinobacteria and has been isolated from various environments worldwide. However, little is known about whether biogeography affects distributional pattern of Streptomyces in salty environments. Such information is essential for understanding the ecology of Streptomyces. Here we analyzed four house-keeping genes (16S rRNA, rpoB, recA and atpD) and salty-tolerance related genes (ectA-ectD) of 38 Streptomyces strains isolated from saline environments in Yunnan and Xinjiang Provinces of western China. The obtained Streptomyces strains were classified into three operational taxonomic units, each comprising habitat-specific geno- and ecotype STs. In combination with expressional variations of salty-tolerance related genes, the statistical analyses showed that spatial distance and environmental factors substantially influenced Streptomyces distribution in saline environments: the former had stronger influence at large spatial scales (>700 km), whereas the latter was influential at large (>700 km) and small spatial scales (<700 km). Plus, the quantitative analyses of salty-tolerence related genes (ectA-D) indicated that Streptomyces strains from salt lakes have higher expression of ectA-D genes and could accumulate larger quantities of ectoine and hydroxyectoine than strains from salt mines, which could help them resist to salinity in the hypersaline environments.
Similar content being viewed by others
Introduction
The study of biogeography addresses spatial patterns of species and ecosystems in geographic space or through geological time1. It is widely accepted that macro-organism populations have many similar characteristics and common ancestry and thus possess different geographical distributions due to geographical isolation2. In contrast, debate has been lasting on microbial biogeography in that microorganisms have great potential for global dispersal and adaptability to diverse environments3. However, numerous studies recently reported biogeographic patterns for microbial distributions4,5.
Microbial biogeography is mainly ascribed to two factors: the environmental heterogeneity and spatial distance, either of which alone cannot entirely account for geographic distribution patterns of some widespread bacterial groups6,7. However, little is known about the relative importance of these two factors to shaping microbial biogeography in saline and saline environments. Theoretically, saline environments are suitable for studying impact of environmental effects on bacterial biogeography because of strong environmental selective pressures in such environments8,9. Previous studies have shown that spatial distance and environmental factors contribute differently to shaping microbial biogeography in saline environments with respect to certain microbial groups9,10.
As one group of widespread Actinobacteria, Streptomyces species have drawn extensive attention from microbiologists due to their capacity to produce diverse bioactive compounds such as antibiotics11,12. Many characterized Streptomyces strains were largely recovered from various salty habitats, such as marine environments, deserts, alkaline or saline soils13,14. In these salty environments, Streptomyces spp. underwent a wide range of environmental pressures and thus developed distinct genetic and metabolic features among different habitats15. So in order to understand the underlying reasons for the endemicity of Streptomyces species in various saline environments, it is important to know 1) whether geographic isolation affects distributional pattern of Streptomyces in saline environments and 2) relative importance of spatial distance and environmental factors to shaping Streptomyces distribution in saline environments.
Investigation on biogeography of Streptomyces requires a detailed taxonomic classification of Streptomyces strains from different saline habitats (salt mines vs lakes). High phylogeny resolution can be achieved by multilocus sequence analyses, which combine phylogenies of 16S rRNA and functional housekeeping genes such as rpoB, recA and atpD16. Previous studies have shown that 16S rRNA gene together with rpoB, recA and atpD genes could provide better phylogenetic resolution than one single gene16. Furthermore, the expressional variation of salty-tolerence related genes (ectA-ectD) could show adaptive evolution of Streptomyces strains in saline environments17. Here, we applied a multilocus phylogenetic analysis of four house-keeping genes (16S rRNA, rpoB, recA and atpD) and salty-tolerence related genes (ectA-ectD) to investigate the biogeographic patterns of Streptomyces strains retrieved from the saline environments in Xinjiang and Yunnan Provinces of western China, and assessed relative effects of spatial distance and environmental factors on biogeography and salty-tolerence mechanism of Streptomyces strains from different salty-habitats (salt mines vs lakes) by Q-PCR analyses.
Results
Geochemistry differentiations between two salty-habitat types (salt mines vs lakes)
In Yunnan Province, Heijing, Yunlong and Jiangcheng salt mines are under subtropical monsoon climate, and originated from salty beds or basins formed by ancient lakes more than 120,000 years ago18. The salt ores in the salt mines are rich in sodium chloride as well as potassium chloride. In Xinjiang Province, the Aydingkol and Qijiaojing salt lake were formed from Holocene of the late Quaternary18. As a result of strong evaporation more than 1000 years, most of surface areas of Aydingkol and Qijiaojing salt lakes have been highly mineralized, containing abundant alkaline rock salt (e.g., Glauber’s salt, glauberite, gypsum, sodium chloride)18, but low concentration of potassium salt. Principle component analysis (PCA) showed that the Yunnan sampling sites were different from that of Xinjiang with respect to environmental factors: the sediment chemistry of the Aydingkol and Qijiaojing salt lakes was different from that of the salt mines in Yunnan Province: the former possesses higher salinity, pH and concentrations of Ca2+, Mg2+ and Mn2+ but lower concentrations of trace elements (e.g. K+ and Zn2+) and total phosphorus than the latter (cumulative contribution value = 94%, Fig. 1). In addition, the sampling sites within a salty-habitat type (salt mines or lakes) were different from each other on the basis of climate types, geographic distances, and geochemistry factors (Tables S1 and S2, Fig. 1).
A PCA map showing the 10 sampling sites and their correlation with trace elements.
Note: pH, Cl−, Ca2+, Mg2, K+, Na+, Fe2, Mn2, Cu2, Zn2, Sanlinity, total N (nitrogen) and total P (phosphorus) were used to evaluate the influence of each variable. The longer the arrow, the greater the influence; the smaller the angle between two arrows, the closer their correlation. Solid squares (■) and pright triangles (▲) denote Qijiaojing (QJJ) and Aydingkol (AK) salt lake sites in Xinjiang Province; inverse triangles (▼), diamonds (♦) and black circles (•) denote Jiangcheng (JC), Heijing (HJ), Yunlong(YL) salt mine sites in Yunnan Province, respectively.
Phylogenetic analysis of four house-keeping genes (16S rRNA, rpoB, recA and atpD) and salty-tolerence related genes (ectA-ectD)
A total of 38 Streptomyces strains were retrieved and subjected to phenotypic characterization14 as well as OTU identification. The obtained Streptomyces strains belonged to three OTUs (Streptomyces pratensis, Streptomyces griseus, and Streptomyces lunaelactis) (Table S3). Each of the identified OTUs covered more than eight strains and contained at least one strain from a sampling site (Table S3). The multi-locus sequence typing (MLST) phylogeny showed endemism of Streptomyces strains: each endemic geno- and ecotype ST was specific to a site or one salty-habitat type (salt mines or lakes, Table 1 and Fig. 2 and Fig. S1, Bootstrap value >80%). A total of 23 genotype (Fig. 2A and Fig. S1A) and 19 ecotype STs (Fig. 2B and Fig. S1B) were identified, with either salty habitat type containing at least 10 geno- or ecotype STs (Fig. 2 and Fig. S1, Table 1), and each sampling site including at least 3 geno- or ecotype STs (Table 1 and Table S5).
Maximum Likelihood based Phylogenetic trees of concatenated sequences of four house-keeping genes (indicated by A, 16S rRNA, rpoB, recA and atpD) and salty-tolerented related genes (indicated by B, ectA-D), showing endemism for three Streptomyces OTUs.
Bar, 0.1, ten nucleotide substitutions per 1000 nt; Bootstrap values are shown as percentage of 1000 replicates, and only the bootstrap values above 50% are shown. Solid squares (■) and pright triangles (▲) denote Qijiaojing (QJJ) and Aydingkol (AK) salt lake sites in Xinjiang Province; inverse triangles (▼), diamonds (♦) and black circles (•) denote Jiangcheng (JC), Heijing (HJ), Yunlong(YL) salt mine sites in Yunnan Province, respectively. The geno- and ecotype STs are marked in the clades, and each genotype is supported by high bootstrap value (>80%).
Effects of spatial distance and environmental factors on the geographic patterns of Streptomyces strains
MLST of four housekeeping genes and ectA-D revealed significant correlations of genetic divergence with geographic distance (MLST of four house-keeping genes, R = 0.88, p = 0.02; MLST of four salty-tolerence related genes, R = 0.82, p = 0.031) (Fig. 3). In addition, the closely related geno- or ecotype STs were present within a very small scale (geographic distances within salt mine or saline lake habitat <700 km, the genetic divergences <0.10; and geographic distances within a sampling site <100 km, the genetic divergences <0.05) but not at distant locations (spatial distances between salt mines and lakes >700 km, the genetic divergences >0.10) (Fig. 3). Mantel test (r > 0.5, P < 0.05) showed that the differentiations of ecotype STs were significantly correlated with the geochemistry variations of sediments between Yunnan salt mines and Xinjiang salt lakes (such as, Na+, Mg2+, Cl− and salinity, Table 2).
Mantel correlation between genetic distances of the investigated genes and geographic distance for the three identified Streptomyces OTUs.
(A,B) panels indicate the correlation between geographic distance and genetic distances of concatenated sequences of four house-keeping genes (16S rRNA, rpoB, recA and atpD, r = 0.88, p = 0.02) and salty-tolerented related genes (ectA-D, r = 0.82, p = 0.031), respectively.
The Z-test of four salty-tolerence related genes (ectA-D) by optimum ‘positive selection’ models (M2a and M8) showed that evolutions of these genes in the 38 Streptomyces strains in this study were partially under positive environmental selection (mean dN/dS > 1, respectively, Table 3 and Fig. S3), while the “nearly neutral” model (Mla) indicated that three house-keeping genes (rpoB, recA, and atpD, mean dN/dS < 1, Table 3) experienced a neutral evolution in three Streptomyces OTUs.
Variation of Streptomyces in response to abiotic stress at 5%, 10% and 15% NaCl
With the help of Q-PCR and HPLC, responses of 38 Streptomyces strains to high osmotic stress (up to 5% NaCl) were investigated by means of quantitative expression of ectA-D genes and quantitation of biosynthesis of ectoine and hydroxyectoine. As a result, the expressional variation of ectA-D (especially, ectC-D) revealed strains from Xinjiang salt lakes have higher expression of ectA-D (especially, ectC > 20 fold changes; ectD > 30 fold changes, Fig. 4) and could accumulate larger quantities of ectoine (>10 fold changes, Fig. 5) and hydroxyectoine (>15 fold changes, Fig. 5) in response to high osmotic stress than strains from salt mines in Yunnan at 15% g/ml of NaCl (Fig. 4, ectC > 8 fold changes; ectD > 10 fold changes; Fig. 5, ectoine >5 fold changes and hydroxyectoine >7 fold changes).
Relative expression quantitation of ectA-D genes at 15% of NaCl by Q-PCR.
Solid squares(■), pright triangles (▲), inverse triangles (▼), diamonds (♦) and black circles (•) indicate Streptomyces strains from Qijiaojing (QJJ) and Aydingkol (AK) salt lake sites in Xinjiang Province and Jiangcheng (JC), Heijing (HJ), Yunlong(YL) salt mine sites in Yunnan Province, respectively. Each deviation of fold changes was calculated by comparison expression of ectA-D in Streptomyces cells growing at salt treated ISP3 medium (5% and 15% g/ml of NaCl) with normal (0% g/ml of NaCl) medium.
Relative quantitation of accumulations of ectoine and hydroxyectoine at different concentrations of NaCl by HPLC.
Solid squares (■), pright triangles (▲), inverse triangles (▼), diamonds (♦) and black circles (•) indicate Streptomyces strains from Qijiaojing (QJJ) and Aydingkol (AK) salt lake sites in Xinjiang Province and Jiangcheng (JC), Heijing (HJ), Yunlong(YL) salt mine sites in Yunnan Province, respectively. For estimating fold changes in accumulation of ectoine and hydroxyectoine, 1 fold changes was defined as the accumulation of ectoine and hydroxyectoine in Streptomyces cells that were grown at the ISP3 medium without salt (0% g/ml of NaCl), each deviation of fold changes was calculated by comparing quantitation of ectoine and hydroxyectoine in Streptomyces cells growing at salt treated ISP3 medium (5% and 15% g/ml of NaCl) with normal (0% g/ml of NaCl) medium.
Discussion
Geographic patterns and endemism of Streptomyces geno- and ecotype STs within an OTU
Our study supports previously detected biogeographical patterns among Streptomyces from saline environments, being consistent with the fact that some Streptomyces species have been exclusively isolated from certain habitats to date13,14,19. The patchy distribution of Streptomyces among species and endemic patterns within one species (Fig. 2 and Fig. S1) indicated that biogeography may influence microbial distribution within a species but may not function among species within the genus at a large geographic scale1. The observed endemic distribution of Streptomyces strains was consistent with previous studies about other microbial groups1,8,9. For example, a patchy geographic distribution was found for the bacterial isolates within a homogeneous background (sulfate-reducing sediments from four continents20. Similarly, crenarchaeal assemblages in mesophilic soil habitats were distributed in mosaic patterns of different phylotypes21. Likewise, individual genotypes of purple non-sulfur bacterium Rhodopseudomonas palustris and Nocardiopsis were detected only locally and exhibited patchy distribution at 1 km or 100 km scales9,22.
Relative importance of spatial distance and environmental factors upon endemism of Streptomyces strains
The biogeographic distribution of Streptomyces could be ascribed to spatial distance and environmental factors1,6. However, little is known about the relative importance of spatial distance and environmental factors on the distributional patterns of the three Streptomyces species. In this study, the impact of spatial distance upon endemicity of Streptomyces from salt mines in Yunnan or salt lakes in Xinjiang could be validated by the fact that the closely related geno- or ecotype STs was present within a very small scale of local habitats (geographic distances between salty mines ot lakes <700 km) but not at distant (spatial distances between salty mines and lakes >700 km) habitats (r > 0.80, p < 0.005, Fig. 3). This indicated that spatial distance significantly contribute to the observed biogeographic patterns of Streptomyces strains from different salty habitats, which was consistent with some previous studies1,6,23,24. Previously, spatial distance together with genetic drift or physical isolation was proposed to lead to endemism of microbial populations at a continent scale or from different biotopes24.
Our data suggest that the spatial distance notably resulted in differentiations of Streptomyces strains between two salty-habitat types (spatial distances between salty mines and lakes >700 km, the genetic divergences >0.10; R > 0.80, P < 0.05, Fig. 3). Our study suggested that both environmental parameters and spatial distance played a role in biogeography of Streptomyces strains at the large (between salt mines and salt lakes) scale. However, environmental parameters apparently rather influence microbial endemism local (within a salty-habitat type) scale. In the present study, the genetic differentiations of four salty-tolerence related genes of retrieved Streptomyces strains significantly corresponded to heterogeneities of some cations or anions in the sediments of the studied sampling sites between salt mines and lakes, or even some sampling sites within a salty-habitat type (Na+, Cl−, Mg2+ and salinity, Table 2). This observation was consistent with some previous studies, in which environmental factors rather than spatial distance were shown to cause bacterial variation at a local scale (from 1 km to 100 km)25. Previous studies indicated that Na+, Mg2+, and Cl− were significant in influencing bacterial biogeography at the species (97% OTU) or subspecies (99%) levels26,27. The Na+ ions were important to some halophilic bacteria or alkaliphilic bacteria as they replaced protons and coupled ion to cope with the high external pH, rather than increasing the electric potential difference across the cytoplasmic membrane26. Mg2+ was a chaotropic agent and a limiting factor in the diversity of microbes in the saline environment27. In addition, salinity of sediments was important regulators of some extremozymes in Streptomyces genus, for example, xylanases, alpha amylases, thermoalklotolerant β-1,3-glucanases and cellulases17, which is also consistent with our study in that Streptomyces strains from Xinjiang salt lakes have higher abilities of regulating expression of ectA-D genes (especially, ectC > 20 fold changes; ectD > 30 fold changes, Fig. 4) and biosynthetic potential of larger quantities of (>10 fold changes, Fig. 5) and hydroxyectoine (>15 fold changes, Fig. 5) than strains from Yunnan salt mines at salty-treated ISP3 medium (Fig. 4, ectC > only 8 fold changes and ectD > only 10 fold changes; Fig. 5, ectoine >5 fold changes and hydroxyectoine >7 fold changes). Thus, it is reasonable to observe the significant influence of environmental factors on endemism of Streptomyces strains. Environmental factors influenced some functional genes important for bacterial survival more significantly than house-keeping genes. For example, evolution of ectA-D genes of the obtained Streptomyces strains showed more visible selection within one habitat or one region than the highly conserved house-keeping genes (rpoB, recA and atpD, Table 3 and Fig. S3). While ectB and ectD gene is responsible for biosythesis of hydroxyectoine that could help Streptomyces strains to deal with external osmotic pressure in vitro. Some residues in catalytic regulation domains of ectB and ectD is under positve selection and subjected to resistence to highly salinity from hypersaline environments (Fig. S3). The abiotic pressure (e.g. salinity) could result in comparably more rapid evolution of Streptomyces strains in the ectB and ectD gene than the ectA and C genes (Table 3 and Fig. S3; p value < = 0.05). This observation could be ascribed to the fact that some residues of the four salty-tolerence related genes could be subjected to mutation due to some abiotic stress (eg. salinity) (Table 3 and Fig. S3; p value < = 0.05), which leads to the catalytic regulation function of their biosynthesis of hydroxyectoine17.
In summary, Streptomyces spp. in saline environments possessed geographic distribution patterns between salt mines and lakes. Spatial distance and environmental factors influenced the biogeography distribution of Streptomyces from different slaty-habitats at large (>700 km) and local scales (<700 km), respectively. Furthermore, environmental factors (e.g. salinity) could result in comparably more rapid evolution of Streptomyces strains in some salty-tolerence related genes than highly conserved house-keeping genes.
Material and Methods
Site description and sample collection
In this study, two sites each were sampled at the Heijing saline mine (HJ1, an abandoned salt mine; HJ2, a natural saline spring), Yunlong (YL1, an abandoned salt spring; YL2, a natural saline mine) and the Jiangcheng salt mine (JC1, an abandoned salt mine; JC2 site, a natural saline spring), respectively. Two (AK1 and AK2) and two sites (QJJ1 and QJJ2) were sampled at Aydingkol and Qijiaojing salt lakes, respectively. At each selected sampling site, sediments were sampled at the 10–30 cm depth and collected into sterile 50 ml sterile Falcon centrifuge tubes. GPS coordinates were recorded at each sampling point with a portable meter in the field and were subsequently imported into Map-Source according to the manufacturer’s instructions to measure the geographic distances among the sites. The location map of sampling sites was generated by Google earth 7.1 in the study. Qijiaojing Salt lake is more than 126 km away from Aydingkol Salt Lake in Xinjiang Province; while in Yunnan Province, Heijing Salt Mine is about 560 km away from Jiangcheng Salt Mine, and Yunlong Salt mines is about about 730 Km and 640 Km away from Heijiang and Jiangcheng salt mines. The sampling sites of Xinjiang Province are about 4300 km away from those of Yunnan Province (Table 1 and S1). The samples for microbial cultivation and geochemistry measurement were stored at 4 °C in the field and during transportation.
Geochemistry measurements
The pH and salinity of 10 g sampled sediments were measured with portable meters after sediments being dissolved into 100 mL distilled water. The concentrations of major cations and trace elements in sediments from ten sampling sites were measured by flame atomic absorption spectrometry (HITACHI Z-2310). Total nitrogen of the sediment samples was determined by the semi-micro-Kjeldahl method and total phosphorus of the sediment samples was determined by the alkali fusion–Mo-Sb Anti-spectrophotometric method28. Principle component analysis (PCA) of the studied sediment samples was performed with the use of the R program29.
Isolation of Streptomyces strains
The sediment samples (2 g, wet weight) were dispersed into 18 ml sterilized physiological saline water (con. 0.70%, w/v, equal to bacterial cell physiological salinity) and were incubated at 30 °C for 30 min with shaking at 150 rpm. The resulting slurry was serially diluted with sterilized physiological saline water (NaCl con. 0.70%, w/v). Aliquots (0.2 ml) of each dilution were spread onto petri dishes containing three different media: cellulose-casein multi-salt medium and modified ISP 2 and ISP 3 media8. All the agar plates were supplemented with 5% (w/v) NaCl and potassium dichromate (15 mg/L). The petri dishes were incubated at 37 °C for 4–6 weeks to obtain enough colonies of Actinobacteria strains. Based on the morphologic characteristics of Streptomyces spp. described previously14, some branching myceliums in petri dishes were picked and checked by light microscopy (BH-2; Olympus). Candidate strains were purified on inorganic salts-starch agar supplemented with 2% (w/v) NaCl and cultivated using the ISP3 medium (Difco Laboratories, Detroit, Mich) at 37 °C for four weeks. Genomic DNA of the obtained strains was extracted and 16S rRNA genes were PCR amplified16. PCR amplification of rpoB, recA, atpD and ectA-D genes was performed according to the methods described previously16,17. The amplified PCR products were purified using a TaKaRa DNA fragment purification kit (Ver. 2.0) and were sequenced using an ABI 3100 automated sequencer with primers of four genes (16S rRNA, 27f and 1525r; rpoB, rpoBPF and rpoBPR; recA, recAF and recAR; atpD, atpDF and atpDR; ectA, ectAF and ectAR; ectB, ectBF and ectBR; ectC, ectCF and ectCR; ectD, ectDF and ectDR) at Shanghai Sangon Biotech (Shanghai, China)16,17. The 16S rRNA gene sequences obtained from the candidate strains were compared with reference taxa via the EzTaxon-e database. The sequences similarity levels were calculated between the candidate strains and their related Streptomyces taxa in the EzTaxon-e database30.
Phylogenetic analysis of isolated Streptomyces strains
Multiple alignments and genetic distance calculations were carried out by using CLUSTAL_X5331 after retrieving the reference sequences of Streptomyces type strains from the EzTaxon-e database. The pair-wise similarities between Streptomyces strains were calculated by the software package MEGA 4.032. OTU classification was performed using DOTUR appliying a 97% 16S rRNA sequence similarity cut-off. The 97% identity of 16S rRNA gene sequences corresponded to 70% of DNA-DNA relatedness, which was widely used as the cutoff value for species definition in prokaryotes33. Reference sequences were retrieved from NCBI (National Center for Biotechnology Informatics, http://www.ncbi.nlm.nih.gov) with BLAST (Basic Local Alignment Search Tool, http://blast.ncbi.nlm.nih.gov/Blast.cgi). Subsequently, in order to study the biogeographic pattern of Streptomyces, four house-keeping (16S rRNA, rpoB recA and atpD) were assigned with allele numbers according to the multi-locus sequence typing (MLST) web site (www.mlst.net)16. And a multi-locus sequence type (ST) of concatenated sequences of four house-keeping genes within an OTU was defined as a genotype ST, and a ST of concatenated sequences of ectA-D within an OTU was nominated as one ecotype ST according to their correlation with multi-locus sequence type of four house-keeping genes (16S rRNA, rpoB, recA and atpD). Phylogenies of the concatenated sequences of investigated genes were constructed with Bayesian inference by using the PhyML 1.8.3 software with maximum-likelihood method and Mr Bayes-3.1.234,35. Bootstrap analysis was used to evaluate the stability of tree topology by resampling 1000 times34,36,37.
Biostatistic and bioinformatic analyses on the biogeographic patterns of Streptomyces strains
In order to assess the impact of spatial distances on Streptomyces strains’ dispersal, the correlations between Nei’s unbiased genetic distances of concatenated sequences of the investigated genes (16S rRNA, rpoB, recA, and atpD; ectA-D) and their corresponding geographic distances were analyzed using Mantel tests implemented in the NTSYS package32. Additionally, the relationship between differentiation in sediments geochemistry and variations of endemic geno- and ecotype STs among ten sampling sites were analyzed by simple Mantel test with the R program29. The maximum-likelihood method of Yang, implemented in the codeml program from the PAML package, was applied to analyze the effects of environmental forces on adaptive evolution of Streptomyces strains38. Six models were used to detect positive environmental selection upon evolution of the Streptomyces strains. Each model allows for various dN/dS ratios ω among sites, including the simplest model (M0 or one-ratio model), the ‘nearly neutral’ model (Mla), the positive selection model (M2a), the discrete Model M3, Model M7 (β), and the optimum positively selective Model M8.
Estimating expression quatitation of ectA-D by Q-PCR and analysis of accumulations of ectoine and hydroxyectoine by High performance liquid chromatography (HPLC)
Total RNAs of the each growth condition was extracted from the cells grown in ISP3 medium using Trizol reagent (Invitrogen). One microgram of each RNA sample was used for constructing cDNA after it was treated with RNase-free DNase I (Invitrogen) using a cDNA Synthesis kit (BioRad). Q-PCR amplification of ectA-D and 16S rRNA (internal control) genes was performed according to the methods described previously17. Results were expressed as the normalized ratio of mRNA level of genes of interest (ectA-D) over internal control (16S rRNA gene). R program was employed to estimate the fold changes in expression of ectA-D genes and accumulation of ectoine and hydroxyectoine at 0%, 5% and 15% g/ml of NaCl via heatmap2 package29, each deviation of fold changes was calculated by comparison expression of ectA-D in Streptomyces cells growing at salt treated ISP3 medium (5% and 15% g/ml of NaCl) with normal (0% g/ml of NaCl) medium. And High performance liquid chromatography (HPLC) was employed to evaluate the accumulation of ectoine and hydroxyectoine in Streptomyces cells in response to osmotic stress according to the methods described previously17. For estimating fold changes in accumulation of ectoine and hydroxyectoine, 1 fold changes was defined as the accumulation of ectoine and hydroxyectoine in Streptomyces cells that were grown at the ISP3 medium without salt (0% g/ml of NaCl), each deviation of fold changes was calculated by comparing quantitation of ectoine and hydroxyectoine in Streptomyces cells growing at salt treated ISP3 medium (5% and 15% g/ml of NaCl) with normal (0% g/ml of NaCl) medium.
Additional Information
How to cite this article: Zhao, F. et al. Biogeography and Adaptive evolution of Streptomyces Strains from saline environments. Sci. Rep. 6, 32718; doi: 10.1038/srep32718 (2016).
References
O’Malley, M. A. et al. The nineteenth century roots of ‘everything is everywhere’. Nat. Rev. Microbiol. 5, 647–651 (2007).
Leibold, M. A. et al. The Meta community concept: a framework for multi-scale community ecology. Ecol. Lett. 7, 601–613 (2004).
Baas-Becking, L. G. M. Geobiologie of Inleiding to de Milieukunde. Van Stockum & Zoon, The Hague (1934).
Casamayor, E. O. et al. Changes in archaeal, bacterial and eukaryal assemblages along a salinity gradient by comparison of genetic fingerprinting methods in a multipond solar saltern. Environ. Microbiol. 73, 338–348 (2002).
Campbell, L. et al. The importance of Prochlorococcus to community structure in the central North Pacific Ocean. Limonol. Oceanog 39, 955–961 (1994).
Martiny, J. B. H. et al. Microbial biogeography: putting microorganisms on the map. Nat. Rev. Microbol. 4, 102–112 (2006).
Moore, L. R. et al. Comparative physiology of Synechococcus and Prochlorococcus: influence of light and temperature on growth, pigments, fluorescence and absorptive properties. Mar. Ecol. Prog. Ser. 116, 259–275 (1995).
Pagaling, E. et al. Microbial Biogeography of Six Salt Lakes in Inner Mongolia, China, and a Salt Lake in Argentina. Appl. Environ. Microbiol. 75, 5750–5760 (2009).
He, Song-Tao . et al. Biogeography of Nocardiopsis strains from hypersaline environments of Yunnan and Xinjiang Provinces, western China. Sci.Rep. 5, 13323; doi: 10.1038/srep13323 (2015).
Foti, M. et al. Genetic diversity and biogeography of haloalkaliphilic sulphur-oxidizing bacteria belonging to the genus Thioalkalivibrio. FEMS Microbiol. Ecol. 56, 95–101 (2006).
Berdy, J. Bioactive microbial metabolites. J Antibiot 58, 1–26 (2005).
Clardy, J. et al. New antibiotics from bacterial natural products. Nat Biotechnol 24, 1541–1550 (2006).
Yi Jiang et al. Streptomyces sparsus sp. nov., isolated from a saline and alkaline soil. International journal of systematic and evolutionary microbiology 61(7), 1601–1605 (2011).
Xin-Qing Zhao et al. Streptomyces xinghaiensis sp. nov., isolated from marine sediment. International Journal of Systematic and Evolutionary Microbiology 59, 2870–2874 (2009).
Bursy J. et al. Synthesis and uptake of the compatible solutes ectoine and 5-hydroxyectoine by Streptomyces coelicolor A3(2) in response to salt and heat stresses. Appl Environ Microbiol 74, 7286–7729 (2008).
Yinping Guo et al. A multilocus phylogeny of the Streptomyces griseus 16S rRNA gene clade: use of multilocus sequence analysis for streptomycete systematics. International Journal of Systematic and Evolutionary Microbiology, 58, 149–159 (2008).
Akram Sadeghi et al. Diversity of the ectoines biosynthesis genes in the salt tolerant Streptomyces and evidence for inductive effect of ectoines on their accumulation. Microbiological Research 169(9–10), 699 (2014).
Zhen, Xiyu et al. Salt lakes and their origin in Xinjiang, Chin. J. Oceanol, Ltmnol. 5(2), 172–185 (1987).
Wu, J.-Y. et al. Diversity of Actinobacterial community in saline sediments from Yunnan and Xinjiang, China. Extremophiles 13, 623–632 (2009).
Perez-Jimenez et al. Phylogeography of sulfatereducing bacteria among disturbed sediments, disclosed by analysis of the dissimilatory sulfite reductase genes (dsrAB). Appl. Environ. Microbiol. 71, 1004–1011 (2005).
Schauer, R. et al. Bacterial diversity and biogeography in deep-sea surface sediments of the South Atlantic Ocean. ISME. J. 4, 159–170 (2010).
Bent, S. J. et al. Spatial distribution of Rhodopseudomonas palustris ecotypes on a local scale. Appl. Environ. Microbiol. 69, 5192–5197 (2003).
Papke, R. T. et al. Geographical isolation in hot spring cyanobacteria. Environ. Microbiol. 5, 650–659 (2003).
Escobar-Páramo, P. et al. Evidence for genetic drift in the diversification of a geographically isolated population of the hyperthermophilic archaen Pyrococcus. Mol. Biol. Evol. 22, 2297–2303 (2005).
Ge, Y. et al. Differences in soil bacterial diversity: driven by contemporary disturbances or historical contingencies? ISME. J 2, 254–264 (2008).
Skulachev, V. P. et al. Bacterial energetics at high pH: what happens to the H cycle when the extracellular concentration decreases? Novar. Found. Symp. 221, 200–217 (1999).
Hallsworth, J. E. et al. Limits of life in MgCl2-containing environments: chaotropicity defines the window. Environ. Microbiol. 9, 801–813 (2007).
Yakimov, M. et al. Microbial community of a saline mud volcano at San Biagio-Belpasso, Mt. Etna (Italy). Environ. Microbiol. 4, 249–256 (2002).
Venables, W. N. et al. Modern Applied Statistics with S. Springer-Verlag, New York (2002).
Kim, O. S. et al. Introducing EzTaxon-e: a prokaryotic 16S rRNA Gene sequence database with phylotypes that represent uncultured species. Int. J. Syst. Evol. Microbiol. 62, 716–721 (2012).
Thompson, J. D. et al. The Clustal X windows interface: flexible strategies for multiple sequence alignment aided by quality analysis tools. Nucleic. Acids. Res. 25, 4876–4882 (1997).
Tamura, K. et al. MEGA4: Molecular Evolutionary Genetics Analysis (MEGA) software version 4.0. Mol. Biol. Evol. 24, 1596–1599 (2007).
Stackebrandt, E. & Goebel, B. M. Taxonomic Note: A Place for DNA-DNA Reassociation and16S rRNA Sequence Analysis in the Present Species Definition in Bacteriology. Int. J. Syst. Evol. Microbiol. 44, 846–849 (1994).
David B. J. & Anderson, W. F. A Fast Algorithm for Rendering Space-Filling Molecule Pictures. J. Mol. Graph. 6, 219–220 (1988).
Guindon, S. & Gascuel, O. A simple, fast, and accurate algorithm to estimate large phylogenies by maximum likelihood. Syst. Biol. 52, 696–704 (2003).
Felsenstein, J. Condence limits on phylogenies: an approach using the bootstrap. Evolution 39, 783–791 (1985).
Fitch, W. M. Towards defining the course of evolution: Minimum change for a specific tree topology. Syst. Zool. 20, 406–416 (1971).
Yang, Z. et al. PAML a program package for phylogenetic analysis by maximum likelihood. Comput. Appli. Biosci. 13, 555–556 (1997).
Acknowledgements
This work was supported by the Fund of Key Projects of the Department of Science and Technology of Yunnan Province (Nos. 2014DFA30830)
Author information
Authors and Affiliations
Contributions
F.Z. and S.-T.H. conceived and designed the work; Y.-H.Q., X.Z. and H.-W.Z. performed the experiments; W.L., M.-X.P. and X.-S.Z. retrieved the sequences; D.-Y.C., H.M., W.Q., P.N. and Y.Z. analyzed the data. All of the authors assisted in writing the manuscript, discussed the results and commented on the manuscript.
Ethics declarations
Competing interests
The authors declare no competing financial interests.
Electronic supplementary material
Rights and permissions
This work is licensed under a Creative Commons Attribution 4.0 International License. The images or other third party material in this article are included in the article’s Creative Commons license, unless indicated otherwise in the credit line; if the material is not included under the Creative Commons license, users will need to obtain permission from the license holder to reproduce the material. To view a copy of this license, visit http://creativecommons.org/licenses/by/4.0/
About this article
Cite this article
Zhao, F., Qin, YH., Zheng, X. et al. Biogeography and Adaptive evolution of Streptomyces Strains from saline environments. Sci Rep 6, 32718 (2016). https://doi.org/10.1038/srep32718
Received:
Accepted:
Published:
DOI: https://doi.org/10.1038/srep32718
This article is cited by
-
Unexpected genomic, biosynthetic and species diversity of Streptomyces bacteria from bats in Arizona and New Mexico, USA
BMC Genomics (2021)
-
Phylogeny and bioactivity of epiphytic Gram-positive bacteria isolated from three co-occurring antarctic macroalgae
Antonie van Leeuwenhoek (2018)
-
Intertidal marine sediment harbours Actinobacteria with promising bioactive and biosynthetic potential
Scientific Reports (2017)